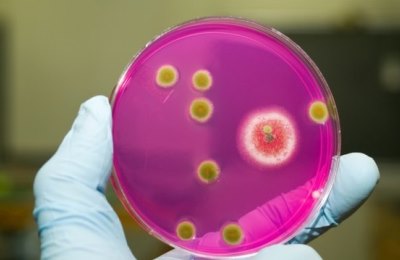

Боль в горле доставляет массу неудобств: невозможно повысить голос, когда это нужно, постоянно хочется пить при першении, сложно кушать и разговаривать. Воспаление миндалин также может давать высокую температуру.
Родители знают, когда у ребенка повышается температура без каких-либо признаков простуды, первым делом нужно осматривать его гланды. Но можно ли при осмотре определить, больное горло или нет, и как оно выглядит у здорового человека?
На первый взгляд, отличить здоровое горло от больного несложно. Для этого достаточно посмотреть его у человека без жалоб на боли в области миндалин и на больное горло. Но также необходимо знать основные признаки нормы лимфоидной ткани миндалин, а также правильно осматривать гланды.
Определение термина «здоровье» для горла
В последнее время даже у ребенка сложно найти не «больное» горло. В школьном возрасте все чаще можно встретить хронические заболевания миндалин, которые к юности только усугубляются.
Дети могут постоянно ходить с фарингитом или тонзиллитом, которые еще и неправильно лечат их родители.
Отоларингологи вывели несколько признаков, по которым каждый родитель может определить здоровое состояние гланд своих и малыша.
- Сначала нужно обратить внимание на состояние и цвет миндалин. Он должен быть светло-розовым.
- Гланды без налета, каких-либо покраснений, имеющие небольшой размер и немного выступающие к маленькому язычку. Иногда бывает так, что миндалины чуть увеличены, но все остальное в норме – бить тревогу не нужно, так как это индивидуальные физиологические особенности.
Так как миндалины не покрыты кожей, а состоят из лимфоидной ткани, то они не идеально гладкие.
Этот орган покрыт маленькими бугорками, но в большинстве своем они не выпячиваются и не переходят куда-либо.
Если миндалина воспалена, тогда бугорки имеют более выраженное состояние.
- Все прилегающие к гландам ткани (небные дужки, мягкое небо, боковые стенки глотки) приблизительно одинакового цвета – розовато-красного. На них нет каких-либо пятен или явных покраснений.
- Важно обратить внимание на контуры миндалин. При здоровом состоянии горла отечность должна отсутствовать.
- При осмотре специалисты обращают внимание на заднюю стенку глотки – она по цвету однородная, нет ярко выраженных сосудов, они не расширены, отсутствуют другие патологические явления.
Врачи отмечают, что различить больное горло от здорового можно по нескольким ключевым признакам. Здоровое горло имеет ровную, светлую слизистую оболочку без покраснений и отеков. При этом больное горло часто сопровождается покраснением, отечностью и наличием налета. Врачи также подчеркивают, что при инфекционных заболеваниях, таких как ангина, может наблюдаться сильная боль при глотании, а температура тела часто повышается. Кроме того, важно обратить внимание на наличие дополнительных симптомов, таких как кашель, насморк или увеличение лимфатических узлов. Если симптомы сохраняются более нескольких дней или усиливаются, рекомендуется обратиться к специалисту для диагностики и назначения лечения.
Диагностические мероприятия
Мы уже знаем, как выглядят здоровые миндалины. Но без практики нельзя сразу же определить, есть ли какое-либо воспаление в горле или нет.
Особенно когда речь идет о здоровье ребенка, важно не пропустить начало какого-либо заболевания.
Для этого у врачей-оториноларингологов есть диагностические способы, с помощью которых можно подтвердить или опровергнуть здоровое состояние миндалин.
-
Анализ на стрептококковую или стафилококковую инфекцию. Для этого в лаборатории берется мазок из горла, можно также взять из носа, так как инфекция не локализуется в каком-то одном месте.
Если высеян стафилококк или стрептококк, горло не может выглядеть здоровым.
При распространении таких инфекций оно обязательно будет с гиперемией, возможно, будут наблюдаться измененные, отечные контуры миндалин и другие признаки больного горла, о которых поговорим ниже.
- Клинический анализ крови, который показывает воспалительный процесс в организме, но не всегда это могут быть проблемы именно с гландами.
-
Сбор анамнеза также важен при диагностике заболевания. Часто встречаются случаи, когда женщина или мужчина может накануне сильно покричать, то пропадает голос. И вина здесь не распространившейся инфекции, а крика.
К слову, осипнуть голос может в результате сильного стресса или у тех, кто неправильно соблюдает питьевой режим (практически не употребляет воду в чистом виде).

Многие люди сталкиваются с проблемой боли в горле, и часто задаются вопросом, как отличить обычное дискомфортное состояние от более серьезного заболевания. В первую очередь, важно обратить внимание на характер боли. Если она острая, сопровождается затруднением при глотании и повышенной температурой, это может указывать на инфекцию, такую как ангина. Также стоит учитывать наличие дополнительных симптомов: кашель, насморк или сыпь могут помочь в определении причины. Некоторые отмечают, что при вирусных инфекциях боль в горле часто проходит сама по себе, тогда как бактериальные инфекции требуют медицинского вмешательства. Не стоит забывать и о том, что аллергия или раздражение от сухого воздуха могут вызывать схожие ощущения, но не требуют лечения антибиотиками. В любом случае, при длительной или сильной боли лучше обратиться к врачу для точной диагностики.
Признаки больного горла
Во время самостоятельной диагностики состояния горла, его осмотре, нужно обратить особое внимание, если:
- мягкое небо гиперемировано, увеличены фолликулы на стенке глотки;
- постоянно беспокоит зуд, иногда называемый першением;
- наблюдаются разрыхленные ткани миндалин и задней стенки глотки, при умеренном покраснении;
проступают сосуды на стенках глотки, они могут быть бледными по цвету, по структуре валики фолликул могут сильно увеличиться в размерах;
- возможно наличие пузырьков, которые по своему виду напоминают герпес, либо язвочки, но эти симптомы следует различать, так как они свидетельствуют о разных заболеваниях;
- может наблюдаться налет гноя на гландах, либо его определенная локализация в складочках, лакунах миндалин;
- увеличенные в размерах гланды, язычок, наличие гнойничков, сочетаемые с температурой и болями в горле свидетельствуют о скором развитии заболевания (ангине), что в свою очередь требует начала антибактериальной терапии;
- если обложены белым налетом не только стенки горла, но и язык, глотка, обратная сторона щек, — это явный признак молочницы (распространение в ротовой полости грибков рода Кандида).
Все эти симптомы свидетельствуют уже о нездоровом состоянии горла.
По ним можно говорить о наличии нескольких заболеваний таких, как фарингит, ангина, молочница, стоматит, лейкоплакия, хронический тонзиллит. Все эти болезни определяет врач и назначает соответствующее лечение.
Поэтому при первых признаках заболевания необходимо сразу обращаться за консультацией специалиста.

Вопрос-ответ
Как определить, какой именно вид болит горло?
Как отличить боль в горле от стрептококковой ангины? Симптомы стрептококковой ангины обычно проявляются довольно быстро. Симптомы простуды и ангины развиваются более постепенно: вы постепенно начинаете чувствовать себя всё хуже и хуже. При стрептококковой ангине других симптомов со стороны верхних дыхательных путей нет.
Как понять, что с горлом что-то не так?
Понять, что с горлом что-то не так, можно по таким симптомам, как боль или дискомфорт при глотании, покраснение и отечность слизистой, появление налета на миндалинах, охриплость голоса, а также повышенная температура и общее недомогание. Если эти симптомы сохраняются более нескольких дней или сопровождаются сильной болью, стоит обратиться к врачу.
Советы
СОВЕТ №1
Обратите внимание на цвет и состояние горла. У здорового горла слизистая оболочка имеет светло-розовый цвет и гладкую поверхность. Если вы заметили покраснение, отек или наличие белых налетов, это может свидетельствовать о воспалении или инфекции.
СОВЕТ №2
Оцените наличие дополнительных симптомов. Больное горло часто сопровождается другими признаками, такими как высокая температура, кашель, головная боль или затрудненное глотание. Если у вас есть несколько из этих симптомов, стоит обратиться к врачу.
СОВЕТ №3
Обратите внимание на характер боли. Если боль в горле острая, резкая и усиливается при глотании, это может указывать на инфекцию. В то время как легкое дискомфортное ощущение может быть связано с сухостью воздуха или аллергией.
СОВЕТ №4
Проверьте, есть ли у вас увеличенные лимфатические узлы. При воспалении горла лимфатические узлы на шее могут увеличиваться и быть болезненными при нажатии. Это также может быть признаком инфекции, требующей медицинского вмешательства.

проступают сосуды на стенках глотки, они могут быть бледными по цвету, по структуре валики фолликул могут сильно увеличиться в размерах;
проступают сосуды на стенках глотки, они могут быть бледными по цвету, по структуре валики фолликул могут сильно увеличиться в размерах;








